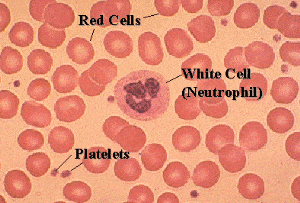

Profile
Simonne Weeks
My CV
-
Education:
Queensland University of Technology
-
Qualifications:
Bachelor of Medical Science
-
Work History:
Hospital pathology labs in Australia and England
-
Current Job:
Lecturer in Biosciences at University of Brighton
-
About Me:
A fun-loving biomedical scientist
-
Read more
Have you ever had a blood test? If you have then I have probably done a biomedical test on it. I can test your blood to find out how many white cells you have and how many red cell you have.
I can also look down a microscope and see if the cells in your blood all look normal like the picture above.
I also use lots of different machines to test blood to check if your kidneys, heart, liver… in fact check if all your organs are working as should to keep you healthy and strong.
Have you ever had a vaccination? I test your blood to make sure you have the right amount of antibodies that can help you fight off any nasty diseases.
-
My Typical Day:
Have breakfast, check emails, deliver lectures or laboratory classes. After work go to the gym or head home and watch Netflix.
-
What I'd do with the prize money:
With the prize money I will help my science students visit and talk to students at local primary and secondary schools. My students come from different backgrounds and have interesting stories about their journey into science at university and where they hope to go next. Sometimes hearing other people’s stories can help you make life changing decisions.
-
My Interview
-
How would you describe yourself in 3 words?
Speedy Imaginative Aussie
What did you want to be after you left school?
Science! of course
Were you ever in trouble at school?
Yes - for talking too much
Who is your favourite singer or band?
Florence and the Machine
What's your favourite food?
Pineapple
If you had 3 wishes for yourself what would they be? - be honest!
Be kinder to myself: Worry less: Have no regrets
Tell us a joke.
If the Silver Surfer and Iron Man team up, they'd be alloys. :)
-